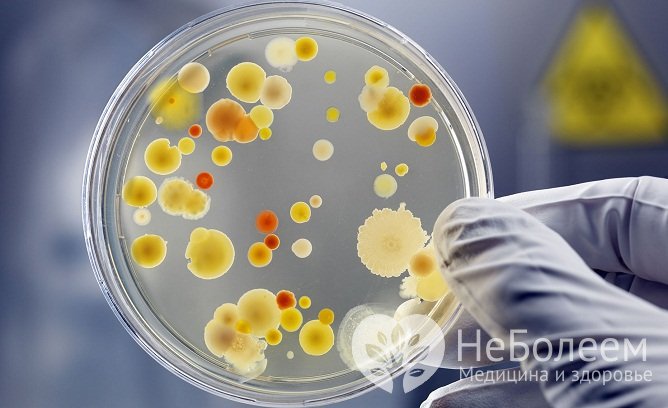
Бакпосев мокроты позволяет выявить инфекционного агента астматического бронхита

Воспользуйтесь поиском по сайту:
Астматический бронхит
Содержание статьи:
Астматический бронхит – это воспалительное заболевание инфекционной и/или аллергической этиологии, при котором патологический процесс обычно протекает в слизистой оболочке крупных и средних бронхов. Чаще всего астматический бронхит диагностируется у детей дошкольного и младшего школьного возраста, особенно при наличии в анамнезе аллергических заболеваний (аллергический ринит, аллергический диатез, атопический дерматит и др.).
 Патогенез астматического бронхита
Патогенез астматического бронхитаПричины и факторы риска
Причиной развития астматического бронхита является повышенная чувствительность к аллергенам, которые попадают в организм аэробронхогенным путем или через желудочно-кишечный тракт.
Инфекционными агентами при астматическом бронхите могут быть бактерии, вирусы, микроскопические грибки. Наиболее часто при астматическом бронхите инфекционного происхождения у пациентов обнаруживается патогенный стафилококк. Астматический бронхит часто развивается на фоне таких заболеваний, как острые респираторные вирусные инфекции, корь, коклюш, ларингит, трахеит, бронхит, пневмония, ГЭРБ (гастроэзофагеальная рефлюксная болезнь).
 Чаще всего астматический бронхит инфекционной этиологии обусловлен патогенным стафилококком
Чаще всего астматический бронхит инфекционной этиологии обусловлен патогенным стафилококкомК неинфекционным аллергенам относятся некоторые продукты питания, домашняя пыль, шерсть и слущенные частички кожи домашних животных, пух, пыльца растений. Причиной развития астматического бронхита у детей могут становиться проведенные вакцинации и прием лекарственных препаратов, вызвавших аллергическую реакцию. Немаловажное значение в развитии астматического бронхита имеет наследственный фактор – нередко заболевание имеет семейный анамнез.
Формы заболевания
Астматический бронхит подразделяют на острый и хронический.
Кроме того, выделяют следующие формы астматического бронхита:
- атопическая (отечность слизистой оболочки стенок бронхов, сужение сегментарных бронхов, обильный слизистый секрет в просвете бронхов);
- инфекционно-аллергическая (изменения в бронхах являются типичными для бронхитов инфекционной этиологии – отек слизистой оболочки бронхов, гиперемия, слизисто-гнойное содержимое в просвете бронхов).
При частых рецидивах астматический бронхит способен трансформироваться в бронхиальную астму. Такая трансформация наблюдается примерно в 30% случаев.
Симптомы астматического бронхита
Для астматического бронхита характерно волнообразное течение с периодами ремиссий, сменяющихся обострениями. В зависимости от аллергического фактора, вызвавшего заболевание, обострения астматического бронхита могут возникать в весенне-летнее или осенне-зимнее время года. Острый период при астматическом бронхите может продолжаться от нескольких часов до месяца.
В период обострения симптомами астматического бронхита являются приступы кашля, которые могут быть спровоцированы физической нагрузкой, смехом, плачем и пр. Перед приступом кашля больные иногда отмечают недомогание, першение в горле, заложенность носа, выделения из носа. Приступу кашля сопутствуют затрудненное дыхание, свистящий выдох, затруднение выдоха (экспираторная одышка). В конце приступа отходит мокрота, и состояние пациента улучшается. Кашель при астматическом бронхите может меняться с сухого на влажный на протяжении суток.
 При обострении астматического бронхита больного мучают приступы кашля
При обострении астматического бронхита больного мучают приступы кашляГрудная клетка не увеличена. Отмечаются сухие или влажные хрипы, которые нередко слышны не только при проведении аускультации, но даже на расстоянии. Температура тела может подниматься до субфебрильных цифр, но чаще находится в границах нормы. По причине того, что патологический процесс протекает в бронхах среднего и крупного калибра, а мелкие бронхи им не затрагиваются, отсутствуют выраженные приступы бронхоспазма (удушья) – это отличает астматический бронхит от астмы.
В случае неинфекционной этиологии заболевания приступы кашля прекращаются с устранением аллергического фактора.
Особенности протекания астматического бронхита у детей
Астматический бронхит у детей часто сопровождается появлением на коже характерных для аллергии зудящих высыпаний. Кроме того, нередко присоединяется неврологическая симптоматика: индифферентность, вялость, или, напротив, раздражительность, капризность, а также повышенная потливость.
Астматическому бронхиту у детей часто сопутствуют другие аллергические процессы, такие как аллергический диатез, атопический дерматит, сезонный аллергический риноконъюнктивит и т. д.
 У детей астматический бронхит часто сопровождается аллергическими высыпаниями на коже
У детей астматический бронхит часто сопровождается аллергическими высыпаниями на кожеЧитайте также:
Диагностика
Диагностика астматического бронхита включает сбор жалоб и анамнеза, проведение физикального и инструментального обследования, скарификационных аллергологических проб, а также ряда лабораторных исследований.
При перкуссии над легкими отмечается коробочный оттенок звука. В ходе аускультации определяется жесткое дыхание, сухие свистящие хрипы, а также мелко- и крупнопузырчатые влажные хрипы.
Анализ крови выявляет повышение количества эозинофилов, повышенное содержание гистамина, IgA, IgE, снижение титра комплемента.
Бакпосев мокроты позволяет выявить инфекционного агента астматического бронхита
Бакпосев мокроты позволяет выявить инфекционного агента астматического бронхитаС целью обнаружения инфекционного агента при астматическом бронхите проводится бактериологический посев мокроты с определением чувствительности возбудителя к антибиотикам (антибиотикограмма). Также может быть назначено бактериологическое исследование промывных вод бронхов.
По результатам рентгенографии легких определяется усиление легочного рисунка в прикорневых зонах, сгущение легочного рисунка в медиальных отделах и разрежение в латеральных.
При проведении эндоскопического исследования в зависимости от наличия или отсутствия инфекционно-воспалительного процесса могут определяться признаки катарального или катарально-гнойного эндобронхита или же практически неизмененная слизистая оболочка стенок бронхов.
Чаще всего астматический бронхит диагностируется у детей дошкольного и младшего школьного возраста, особенно при наличии в анамнезе аллергических заболеваний.
Оценка степени бронхообструкции проводится при помощи исследования функций внешнего дыхания:
- газоаналитическое исследование внешнего дыхания;
- измерение пиковой скорости выдоха (пикфлоуметрия);
- измерение объемных и скоростных показателей дыхания (спирометрия);
- исследование механики внешнего дыхания (плетизмография, пневмотахография).
Лечение астматического бронхита
Схема лечения астматического бронхита подбирается в зависимости от формы заболевания, а также индивидуальных особенностей пациента.
В первую очередь необходимо устранить воздействие аллергена, который вызвал развитие заболевания. Эффективным является проведение длительной специфической гипосенсибилизации выявленным аллергеном, особенно в тех случаях, когда невозможно прекратить контакт пациента с причинным аллергеном. Лечебная доза аллергена постепенно увеличивается до достижения максимального уровня, переносимого пациентом. После этого проводится лечение поддерживающими дозировками в течение двух лет и дольше. Специфическая гипосенсибилизация позволяет предотвратить трансформацию астматического бронхита в бронхиальную астму.
Больным астматическим бронхитом назначаются бронхолитические и спазмолитические препараты, муколитики, антигистаминные лекарственные средства, витаминные комплексы. При подтверждении инфекционного процесса применяются противоинфекционные препараты, выбор которых осуществляется в зависимости от вида возбудителя.
В комплексное лечение входит небулайзерная (ингаляционная) терапия, эффективны щелочные ингаляции, а также ингаляции с использованием хлористо-натриевой термальной минеральной воды.
После стихания острой симптоматики назначается физиотерапия: общий и локальный массаж грудной клетки, перкуторный массаж, гидропроцедуры, электрофорез, УФО-терапия, акупунктура, электроакупунктура.
 В состав лечения астматического бронхита входит небулайзерная терапия
В состав лечения астматического бронхита входит небулайзерная терапияБольным показана гипоаллергенная диета и соблюдение водного режима (обильное питье).
При тяжелом течении заболевания пациенту может потребоваться госпитализация.
Больным астматическим бронхитом показано диспансерное наблюдение. В период ремиссии пациентам рекомендуется санаторно-курортное оздоровление.
Возможные осложнения и последствия
При частых рецидивах астматический бронхит способен трансформироваться в бронхиальную астму. Такая трансформация наблюдается примерно в 30% случаев.
Прогноз
При своевременной диагностике и правильно подобранном лечении прогноз благоприятный.
Профилактика
В целях предупреждения развития астматического бронхита, а также профилактики рецидивов рекомендуется:
- устранение аллергического фактора из окружения больного;
- проведение специфической и неспецифической гипосенсибилизации;
- устранение хронических очагов инфекции в организме;
- проведение комплекса упражнений лечебной физкультуры;
- закаливание;
- сбалансированное питание;
- отказ от вредных привычек.
Об авторе

Информация является обобщенной и предоставляется в ознакомительных целях. При первых признаках болезни обратитесь к врачу. Самолечение опасно для здоровья!
При регулярном посещении солярия шанс заболеть раком кожи увеличивается на 60%.
























